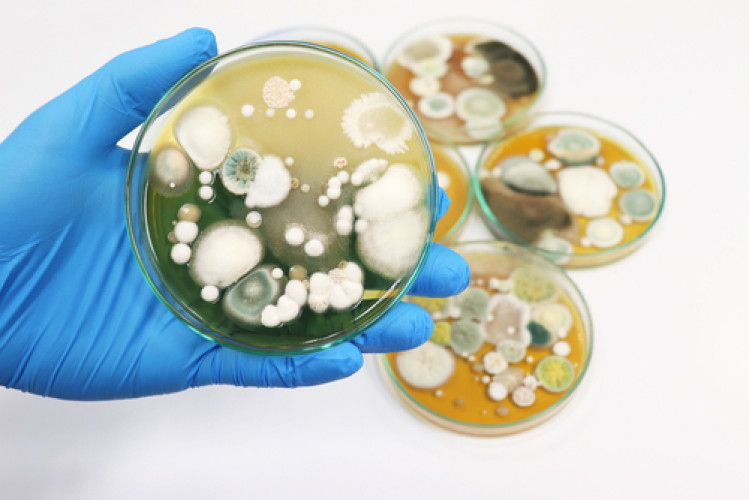

News
Jun 20, 2022 - Foods
Yeasts and molds in food – express testing also available
Yeasts and molds are widespread in our environment (soil, plants, air, water, humans...) and are therefore found in many foods. While they are desirable in some foods (beer, baked goods, mold cheese...), they lead to spoilage in other foods.
How many yeasts and molds in food are still tolerable depends on the respective food group. However, if these values are exceeded, this indicates possible spoilage of the food.
You can also find more information in our compact fact sheets on yeasts and molds or on the website of LGL Bayern.
Unlike most bacteria, many yeasts and molds have the special ability to grow even at low water contents and/or low pH levels. These yeasts and molds can be specifically tested using certain methods.
At the BAV Institute, we offer these and other analyses for yeasts and molds. In addition to quantitative and qualitative analyses, we can also offer you the identification of grown colonies. If there is a particular need for speed, our laboratory also conducts a quantitative rapid method. With this, you receive the results two days earlier. We provide you with fast and reliable results.
For questions, our customer advisors are very happy to assist you.